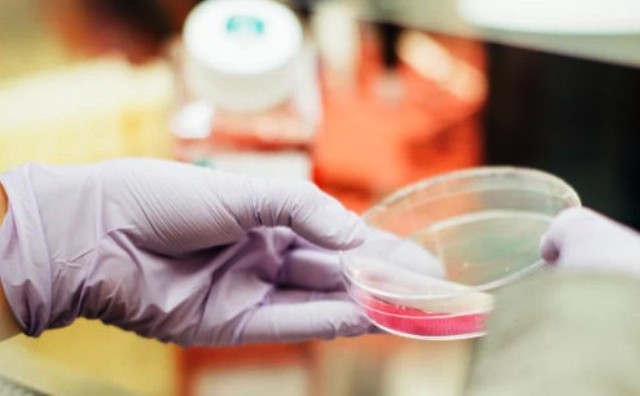

Ερευνητές της Ιατρικής Σχολής του Πανεπιστημίου Στάνφορντ στην Καλιφόρνια ανακοίνωσαν ότι κατάφεραν να αναζωογονήσουν ανθρώπινα γερασμένα κύτταρα, αναπρογραμματίζοντας τα, ώστε να επιστρέψουν σε νεανική κατάσταση.
Το σημαντικό επίτευγμα στο πεδίο της αναγεννητικής ιατρικής, αν και ακόμη σε αρχικό στάδιο, ελπίζεται ότι θα βοηθήσει μελλοντικά στη θεραπεία ασθενειών όπως η οστεοαρθρίτιδα και η μυϊκή ατροφία, που προκαλούνται από την κυτταρική γήρανση.
Μια βασική αιτία της γήρανσης θεωρείται η συσσώρευση σφαλμάτων στο επιγονιδίωμα, στο σύστημα πρωτεϊνών που «πακετάρει» το DNA και ελέγχει την πρόσβαση στα γονίδια. Οι ερευνητές, με επικεφαλής τον επίκουρο καθηγητή Βιτόριο Σεμπαστιάνο, που έκαναν τη σχετική δημοσίευση στο περιοδικό “Nature Communications”, σύμφωνα με τους «Τάιμς της Νέας Υόρκης», βρήκαν τρόπο να αναστρέψουν αυτά τα σφάλματα, σαν να μην είχαν γίνει ποτέ, και έτσι να επιστρέψουν τα κύτταρα σε νεανική κατάσταση.
Όπως ανέφεραν, η μέθοδος τους «αποτελεί ένα σημαντικό βήμα προς το στόχο της αναστροφής της κυτταρικής γήρανσης» και θα μπορούσε να ανοίξει νέους δρόμους θεραπείας για ασθένειες σχετικές με τη γήρανση, αλλά και για την ίδια τη γήρανση. Όμως θα χρειαστεί αρκετός χρόνος, ώσπου να επιτευχθεί κάτι τέτοιο μέσω φαρμάκων.
Η ελπιδοφόρα τεχνική χρησιμοποιεί ορισμένες πρωτεΐνες, τους λεγόμενους «παράγοντες Γιαμανάκα» (από το όνομα του πρωτοπόρου Ιάπωνα επιστήμονα που πήρε το Νόμπελ Ιατρικής 2012 επειδή άνοιξε το δρόμο για το νεανικό αναπρογραμματισμό των κυττάρων) για να αναπρογραμματίσει το επιγονιδίωμα του κυττάρου και να το επαναφέρει χρονικά στο σημείο «μηδέν» της εμβρυικής κατάστασης. Οι «παράγοντες Γιαμανάκα», σύμφωνα με προηγούμενες έρευνες σε τρωκτικά, κρύβουν κινδύνους και θα μπορούσαν να πυροδοτήσουν καρκινική ανάπτυξη, αλλά οι επιστήμονες στις ΗΠΑ βρήκαν τρόπο να αποφεύγουν κάτι τέτοιο.
Οι ερευνητές του Στάνφορντ πήραν γερασμένα κύτταρα χόνδρου από ασθενείς με οστεοαρθρίτιδα και, μετά την προσθήκη μιας μικρής δόσης «παραγόντων Γιαμανάκα» στο εργαστήριο, τα κύτταρα έπαυσαν να εμφανίζουν φλεγμονή και να προκαλούν τη νόσο. Κάτι ανάλογο πέτυχαν με ανθρώπινα βλαστικά κύτταρα από ανθρώπους με μυϊκή ατροφία, καθώς και με γερασμένα ποντίκια που ανέκτησαν νεανική μυϊκή δύναμη.
Οι ερευνητές δημιούργησαν ήδη την εταιρεία βιοτεχνολογίας Turn Biotechnologies για να αναπτύξουν νέου τύπου θεραπείες με βάση τη μέθοδο τους. Προηγουμένως όμως θα πρέπει να διασφαλίσουν με νέες μεγαλύτερες μελέτες ότι η τεχνική τους είναι απολύτως ασφαλής.
Σύνδεσμος για την επιστημονική δημοσίευση:
https://www.nature.com/articles/s41467-020-15174-3
Παύλος Δρακόπουλος / ΑΠΕ ΜΠΕ/ photo unsplash